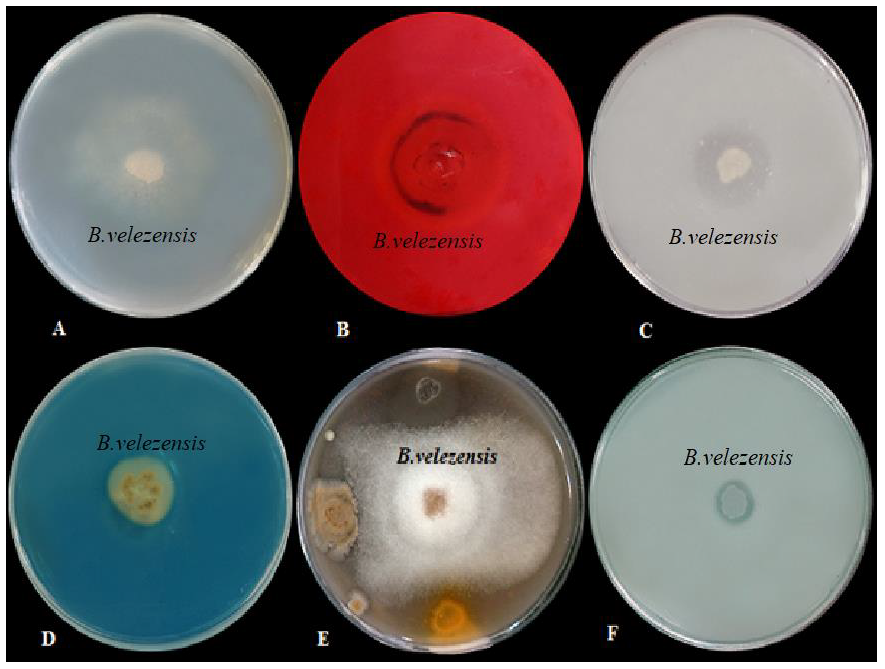
Materials 15 02114 g002 Materials 15 02114 g002

Sodium Alginate–Gelatin Nanoformulations for Encapsulation of Bacillus velezensis and Their Use for Biological Control of Pistachio Gummosis
Abstract
1. Introduction
2. Materials and Methods
2.1. Pathogen (Phytophthora drechsleri) Isolates
2.2. PGPR Bacterial Strain
2.3. In Vitro Inhibitory Potential of B. velezensis
2.4. Evaluation of Plant Growth-Promoting and Biocontrol Properties of B. velezensis
2.5. Encapsulation Procedure
2.5.1. Materials
2.5.2. Extraction of ALG
2.5.3. Purification of ALG Extracts
2.5.4. Chemical Structure of the Extracted ALG
2.5.5. Physicochemical Properties of ALG
2.5.6. Synthesis of SiO2 Nanoparticles
2.5.7. Evaluation of the Antibacterial Activity of Nanoparticles (SiO2 and CNTs)
2.5.8. Preparation of the ALG-Gelatin Microcapsules
2.5.9. Efficiency of ALG-Gelatin Beads
2.5.10. Characterization of the ALG-Gelatin Microcapsules
2.5.11. X-ray Diffraction (XRD) Analysis
2.5.12. Viability of Microencapsulated Bacteria after One Year
2.5.13. Assessment of B. velezensis Release and Viability in Soil
2.6. Greenhouse Experiments
2.6.1. Preparation of the Bacterial Inoculant
2.6.2. Planting and Growth Conditions of Pistachio Plants
2.6.3. Growth Factor Measurement
2.6.4. Disease Control
2.7. Statistical Analysis
3. Results and Discussion
3.1. Effect of Bacterial Strains on In Vitro Mycelial Growth of P. drechsleri
3.2. Cellulase Activities of B. velezensis
3.3. Protease and Lipase Activities of B. velezensis
3.4. Siderophore Production by B. velezensis
3.5. Solubilization of Phosphorus
3.6. Determination of IAA Production
3.7. 1H NMR Spectra of the Extracted ALG
3.8. FTIR Spectra of ALG Samples
3.9. The Physiochemical Properties of ALG
3.10. Efficiency of Nanoparticle Encapsulation of B. velezensis
3.11. X-ray Diffraction Analysis
3.12. Microscopy Study of ALG-Gelatin Microcapsules
3.13. Assessment of the Extent of Bacterial Release and Viability in Soil
3.14. Evaluation of the B. velezensis Survival Rate in Microcapsules after One Year of Storage
3.15. Greenhouse Experiments
4. Conclusions
Author Contributions
Funding
Institutional Review Board Statement
Informed Consent Statement
Data Availability Statement
Conflicts of Interest
References
- Burgain, J.; Gaiani, C.; Linder, M.; Scher, J. Encapsulation of probiotic living cells: From laboratory scale to industrial applications. J. Food Eng. 2011, 104, 467–483. [Google Scholar] [CrossRef]
- Riseh, R.S.; Ebrahimi-Zarandi, M.; Gholizadeh Vazvani, M.; Skorik, Y.A. Reducing drought stress in plants by encapsulating plant growth-promoting bacteria with polysaccharides. Int. J. Mol. Sci. 2021, 22, 12979. [Google Scholar] [CrossRef] [PubMed]
- Riseh, R.S.; Skorik, Y.A.; Thakur, V.K.; Pour, M.M.; Tamanadar, E.; Noghabi, S.S. Encapsulation of plant biocontrol bacteria with alginate as a main polymer material. Int. J. Mol. Sci. 2021, 22, 11165. [Google Scholar] [CrossRef] [PubMed]
- Maruyama, C.R.; Bilesky-Jose, N.; de Lima, R.; Fraceto, L.F. Encapsulation of Trichoderma harzianum preserves enzymatic activity and enhances the potential for biological control. Front. Bioeng. Biotechnol. 2020, 8, 225. [Google Scholar] [CrossRef]
- Pour, M.M.; Saberi-Riseh, R.; Mohammadinejad, R.; Hosseini, A. Investigating the formulation of alginate-gelatin encapsulated Pseudomonas fluorescens (vupf5 and t17-4 strains) for controlling Fusarium solani on potato. Int. J. Biol. Macromol. 2019, 133, 603–613. [Google Scholar] [CrossRef]
- Pour, M.M.; Saberi-Riseh, R.; Mohammadinejad, R.; Hosseini, A. Nano-encapsulation of plant growth-promoting rhizobacteria and their metabolites using alginate-silica nanoparticles and carbon nanotube improves ucb1 pistachio micropropagation. J. Microbiol. Biotechnol. 2019, 29, 1096–1103. [Google Scholar]
- Rohman, S.; Kaewtatip, K.; Kantachote, D.; Tantirungkij, M. Encapsulation of Rhodopseudomonas palustris ktssr54 using beads from alginate/starch blends. J. Appl. Polym. Sci. 2021, 138, 50084. [Google Scholar] [CrossRef]
- Rosas-Flores, W.; Ramos-Ramírez, E.G.; Salazar-Montoya, J.A. Microencapsulation of Lactobacillus helveticus and Lactobacillus delbrueckii using alginate and gellan gum. Carbohydr. Polym. 2013, 98, 1011–1017. [Google Scholar] [CrossRef]
- Saberi-Rise, R.; Moradi-Pour, M. The effect of Bacillus subtilis vru1 encapsulated in alginate-bentonite coating enriched with titanium nanoparticles against Rhizoctonia solani on bean. Int. J. Biol. Macromol. 2020, 152, 1089–1097. [Google Scholar] [CrossRef]
- Vaziri, A.S.; Alemzadeh, I.; Vossoughi, M.; Khorasani, A.C. Co-microencapsulation of Lactobacillus plantarum and dha fatty acid in alginate-pectin-gelatin biocomposites. Carbohydr. Polym. 2018, 199, 266–275. [Google Scholar] [CrossRef]
- Yue, W.; Zhang, H.H.; Yang, Z.N.; Xie, Y. Preparation of low-molecular-weight sodium alginate by ozonation. Carbohydr Polym 2021, 251, 117104. [Google Scholar] [CrossRef] [PubMed]
- Tu, L.; He, Y.; Yang, H.; Wu, Z.; Yi, L. Preparation and characterization of alginate-gelatin microencapsulated Bacillus subtilis sl-13 by emulsification/internal gelation. J. Biomater. Sci. Polym. Ed. 2015, 26, 735–749. [Google Scholar] [CrossRef] [PubMed]
- Al-aghabary, K.; Zhu, Z.; Shi, Q. Influence of silicon supply on chlorophyll content, chlorophyll fluorescence, and antioxidative enzyme activities in tomato plants under salt stress. J. Plant Nutr. 2004, 27, 2101–2115. [Google Scholar] [CrossRef]
- Ahmadian, K.; Jalilian, J.; Pirzad, A. Nano-fertilizers improved drought tolerance in wheat under deficit irrigation. Agric. Water Manag. 2021, 244, 106544. [Google Scholar] [CrossRef]
- Vishwakarma, K.; Upadhyay, N.; Kumar, N.; Tripathi, D.K.; Chauhan, D.K.; Sharma, S.; Sahi, S. Potential applications and avenues of nanotechnology in sustainable agriculture. In Nanomaterials in Plants, Algae, and Microorganisms; Academic Press: Cambridge, UK, 2018; Volume 1, pp. 473–500. [Google Scholar]
- Khodakovskaya, M.; Dervishi, E.; Mahmood, M.; Xu, Y.; Li, Z.; Watanabe, F.; Biris, A.S. Carbon nanotubes are able to penetrate plant seed coat and dramatically affect seed germination and plant growth. ACS Nano 2009, 3, 3221–3227. [Google Scholar] [CrossRef] [PubMed]
- Errakhi, R.; Bouteau, F.; Lebrihi, A.; Barakate, M. Evidences of biological control capacities of Streptomyces spp. Against Sclerotium rolfsii responsible for damping-off disease in sugar beet (Beta vulgaris L.). World J. Microbiol. Biotechnol. 2007, 23, 1503–1509. [Google Scholar] [CrossRef]
- Patten, C.L.; Glick, B.R. Bacterial biosynthesis of indole-3-acetic acid. Can. J. Microbiol. 1996, 42, 207–220. [Google Scholar] [CrossRef]
- Arora, N.K.; Verma, M. Modified microplate method for rapid and efficient estimation of siderophore produced by bacteria. 3 Biotech 2017, 7, 381. [Google Scholar] [CrossRef]
- Son, H.J.; Park, G.T.; Cha, M.S.; Heo, M.S. Solubilization of insoluble inorganic phosphates by a novel salt- and ph-tolerant Pantoea agglomerans r-42 isolated from soybean rhizosphere. Bioresour. Technol. 2006, 97, 204–210. [Google Scholar] [CrossRef]
- Ariffin, H.; Abdullah, N.; Umi Kalsom, M.S.; Shirai, Y.; Hassan, M.A. Production and characterization of cellulase by Bacillus pumilus eb3. Int. J. Eng. Technol. 2006, 3, 47–53. [Google Scholar]
- Berg, G.; Krechel, A.; Ditz, M.; Sikora, R.A.; Ulrich, A.; Hallmann, J. Endophytic and ectophytic potato-associated bacterial communities differ in structure and antagonistic function against plant pathogenic fungi. FEMS Microbiol. Ecol. 2005, 51, 215–229. [Google Scholar] [CrossRef] [PubMed]
- Ertugrul, S.; Donmez, G.; Takac, S. Isolation of lipase producing Bacillus sp. From olive mill wastewater and improving its enzyme activity. J. Hazard. Mater. 2007, 149, 720–724. [Google Scholar] [CrossRef] [PubMed]
- Arvizu-Higuera, D.L.; Hernández-Carmona, G.; Rodríguez-Montesinos, Y.E. Effect of the type of precipitation on the process to obtain sodium alginate: Calcium alginate method and alginic acid method. Cienc. Mar. 1997, 23, 195–207. [Google Scholar] [CrossRef]
- Gomez, C.G.; Pérez Lambrecht, M.V.; Lozano, J.E.; Rinaudo, M.; Villar, M.A. Influence of the extraction-purification conditions on final properties of alginates obtained from brown algae (Macrocystis pyrifera). Int. J. Biol. Macromol. 2009, 44, 365–371. [Google Scholar] [CrossRef]
- Sellimi, S.; Younes, I.; Ayed, H.B.; Maalej, H.; Montero, V.; Rinaudo, M.; Dahia, M.; Mechichi, T.; Hajji, M.; Nasri, M. Structural, physicochemical and antioxidant properties of sodium alginate isolated from a tunisian brown seaweed. Int. J. Biol. Macromol. 2015, 72, 1358–1367. [Google Scholar] [CrossRef]
- Ma, J.; Lin, Y.; Chen, X.; Zhao, B.; Zhang, J. Flow behavior, thixotropy and dynamical viscoelasticity of sodium alginate aqueous solutions. Food Hydrocoll. 2014, 38, 119–128. [Google Scholar] [CrossRef]
- Gómez-Ordóñez, E.; Rupérez, P. Ftir-atr spectroscopy as a tool for polysaccharide identification in edible brown and red seaweeds. Food Hydrocoll. 2011, 25, 1514–1520. [Google Scholar] [CrossRef]
- Li, Z.; Hou, B.; Xu, Y.; Wu, D.; Sun, Y. Hydrothermal synthesis, characterization, and photocatalytic performance of silica-modified titanium dioxide nanoparticles. J. Colloid Interface Sci. 2005, 288, 149–154. [Google Scholar] [CrossRef]
- Abbaszadegan, A.; Ghahramani, Y.; Gholami, A.; Hemmateenejad, B.; Dorostkar, S.; Nabavizadeh, M.; Sharghi, H. The effect of charge at the surface of silver nanoparticles on antimicrobial activity against gram-positive and gram-negative bacteria: A preliminary study. J. Nanomater. 2015, 2015, 720654. [Google Scholar] [CrossRef]
- Young, C.C.; Rekha, P.D.; Lai, W.A.; Arun, A.B. Encapsulation of plant growth-promoting bacteria in alginate beads enriched with humic acid. Biotechnol. Bioeng. 2006, 95, 76–83. [Google Scholar] [CrossRef]
- Wu, Z.; Guo, L.; Qin, S.; Li, C. Encapsulation of r. Planticola rs-2 from alginate-starch-bentonite and its controlled release and swelling behavior under simulated soil conditions. J. Ind. Microbiol. Biotechnol. 2012, 39, 317–327. [Google Scholar] [CrossRef] [PubMed]
- Szybalski, W.; Bryson, V. Genetic studies on microbial cross resistance to toxic agents. I. Cross resistance of escherichia coli to fifteen antibiotics. J. Bacteriol. 1952, 64, 489–499. [Google Scholar] [CrossRef] [PubMed]
- Moradi, M. Isolation and Identification of Phytophthora species from Root and Crown of Pistachio in Kerman and Fars Provinces and Resistance Determination of Root and Crown among Current Pistachio Cultivars. Master’s Thesis, Shiraz University, Shiraz, Iran, 1998. [Google Scholar]
- Thomas, C.; Inaba, T.; Cohen, Y. Physiological specialization in Pseudoperonospora cubensis. Phytopathology 1987, 77, 1621–1624. [Google Scholar] [CrossRef]
- Tenorio-Salgado, S.; Tinoco, R.; Vazquez-Duhalt, R.; Caballero-Mellado, J.; Perez-Rueda, E. Identification of volatile compounds produced by the bacterium Burkholderia tropica that inhibit the growth of fungal pathogens. Bioengineered 2013, 4, 236–243. [Google Scholar] [CrossRef] [PubMed]
- Ma, Z.; Zhang, S.; Sun, K.; Hu, J. Identification and characterization of a cyclic lipopeptide iturin a from a marine-derived Bacillus velezensis 11-5 as a fungicidal agent to Magnaporthe oryzae in rice. J. Plant Dis. Prot. 2020, 127, 15–24. [Google Scholar] [CrossRef]
- Parewa, H.P.; Meena, V.S.; Jain, L.K.; Choudhary, A. Sustainable crop production and soil health management through plant growth-promoting rhizobacteria. In Role of Rhizospheric Microbes in Soil: Stress Management and Agricultural Sustainability; 2018; Volume 1, pp. 299–329. Available online: https://link.springer.com/chapter/10.1007/978-981-10-8402-7_12 (accessed on 7 March 2022).
- Yadav, A.N.; Kour, D.; Rana, K.L.; Kumar, V.; Dhaliwa, S.; Verma, P.; Singh, B.; Chauahan, V.S.; Sugitha, T.C.K.; Saxena, A.K. Plant microbiomes and its beneficial multifunctional plant growth promoting attributes. Int. J. Environ. Sci. Nat. Resour. 2017, 3, 1–8. [Google Scholar] [CrossRef]
- Zhao, R.; Sun, J.; Torley, P.; Wang, D.; Niu, S. Measurement of particle diameter of Lactobacillus acidophilus microcapsule by spray drying and analysis on its microstructure. World J. Microbiol. Biotechnol. 2008, 24, 1349–1354. [Google Scholar] [CrossRef]
- Javed, S.; Azeem, F.; Hussain, S.; Rasul, I.; Siddique, M.H.; Riaz, M.; Afzal, M.; Kouser, A.; Nadeem, H. Bacterial lipases: A review on purification and characterization. Prog. Biophys. Mol. Biol. 2018, 132, 23–34. [Google Scholar] [CrossRef]
- Ismail, A.R.; El-Henawy, S.B.; Younis, S.A.; Betiha, M.A.; El-Gendy, N.S.; Azab, M.S.; Sedky, N.M. Statistical enhancement of lipase extracellular production by Bacillus stratosphericus psp8 in a batch submerged fermentation process. J. Appl. Microbiol. 2018, 125, 1076–1093. [Google Scholar] [CrossRef]
- Hasan, N.a.; Nawahwi, M.Z.; Yahya, N.I.A.; Othman, N. Identification and optimization of lipase producing bacteria from palm oil contaminated waste. J. Fundam. Appl. Sci. 2018, 10, 300–310. [Google Scholar]
- dos Santos, M.L.; Berlitz, D.L.; Wiest, S.L.F.; Schünemann, R.; Knaak, N.; Fiuza, L.M. Benefits associated with the interaction of endophytic bacteria and plants. Braz. Arch. Biol. Technol. 2018, 61, 1–11. [Google Scholar] [CrossRef]
- Rocha, F.Y.O.; Oliveira, C.M.D.; da Silva, P.R.A.; Melo, L.H.V.D.; Carmo, M.G.F.D.; Baldani, J.I. Taxonomical and functional characterization of Bacillus strains isolated from tomato plants and their biocontrol activity against races 1, 2 and 3 of Fusarium oxysporum f. Sp. Lycopersici. Appl. Soil Ecol. 2017, 120, 8–19. [Google Scholar] [CrossRef]
- Yu, X.; Ai, C.; Xin, L.; Zhou, G. The siderophore-producing bacterium, Bacillus subtilis cas15, has a biocontrol effect on fusarium wilt and promotes the growth of pepper. Eur. J. Soil Biol. 2011, 47, 138–145. [Google Scholar] [CrossRef]
- Misk, A.; Franco, C. Biocontrol of chickpea root rot using endophytic actinobacteria. BioControl 2011, 56, 811–822. [Google Scholar] [CrossRef]
- Sadeghi, A.; Karimi, E.; Dahaji, P.A.; Javid, M.G.; Dalvand, Y.; Askari, H. Plant growth promoting activity of an auxin and siderophore producing isolate of Streptomyces under saline soil conditions. World J. Microbiol. Biotechnol. 2012, 28, 1503–1509. [Google Scholar] [CrossRef]
- Verma, V.C.; Singh, S.K.; Prakash, S. Bio-control and plant growth promotion potential of siderophore producing endophytic Streptomyces from Azadirachta indica a. Juss. J. Basic Microbiol. 2011, 51, 550–556. [Google Scholar] [CrossRef]
- Kumar, A.; Bahadur, I.; Maurya, B.R.; Raghuwanshi, R.; Meena, V.S.; Singh, D.K.; Dixit, J. Does a plant growth promoting rhizobacteria enhance agricultural sustainability? J. Pure Appl. Microbiol. 2015, 9, 715–724. [Google Scholar]
- Gull, M.; Hafeez, F.Y.; Saleem, M.; Malik, K.A. Phosphorus uptake and growth promotion of chickpea by co-inoculation of mineral phosphate solubilising bacteria and a mixed rhizobial culture. Aust. J. Exp. Agric. 2004, 44, 623–628. [Google Scholar] [CrossRef]
- Tsavkelova, E.A.; Cherdyntseva, T.A.; Klimova, S.Y.; Shestakov, A.I.; Botina, S.G.; Netrusov, A.I. Orchid-associated bacteria produce indole-3-acetic acid, promote seed germination, and increase their microbial yield in response to exogenous auxin. Arch. Microbiol. 2007, 188, 655–664. [Google Scholar] [CrossRef]
- Khan, N.; Bano, A.; Ali, S.; Babar, M.A. Crosstalk amongst phytohormones from planta and pgpr under biotic and abiotic stresses. Plant Growth Regul. 2020, 90, 189–203. [Google Scholar] [CrossRef]
- Casey, A.; Farrell, G.F.; McNamara, M.; Byrne, H.J.; Chambers, G. Interaction of carbon nanotubes with sugar complexes. Synth. Met. 2005, 153, 357–360. [Google Scholar] [CrossRef][Green Version]
- Fathi, F.; Riseh, R.S.; Khodaygan, P.; Hosseini, S.; Skorik, Y.A. Microencapsulation of a Pseudomonas strain (VUPF506) in alginate–whey protein–carbon nanotubes and next-generation sequencing identification of this strain. Polymers 2021, 13, 4269. [Google Scholar] [CrossRef] [PubMed]
- Fathi, F.; Saberi-Riseh, R.; Khodaygan, P. Survivability and controlled release of alginate-microencapsulated Pseudomonas fluorescens vupf506 and their effects on biocontrol of Rhizoctonia solani on potato. Int. J. Biol. Macromol. 2021, 183, 627–634. [Google Scholar] [CrossRef]
- Liu, Q.; Chen, B.; Wang, Q.; Shi, X.; Xiao, Z.; Lin, J.; Fang, X. Carbon nanotubes as molecular transporters for walled plant cells. Nano Lett. 2009, 9, 1007–1010. [Google Scholar] [CrossRef]
- Oloumi, H.; Mousavi, E.A.; Mohammadinejad, R. Multi-walled carbon nanotubes enhance Cd2+ and Pb2+ uptake by canola seedlings. Agrochimica 2014, 58, 91–102. [Google Scholar]
- Saberi-Riseh, R.; Moradi-Pour, M. A novel encapsulation of Streptomyces fulvissimus uts22 by spray drying and its biocontrol efficiency against Gaeumannomyces graminis, the causal agent of take-all disease in wheat. Pest Manag. Sci. 2021, 77, 4357–4364. [Google Scholar] [CrossRef] [PubMed]
- Phadke, K.V.; Manjeshwar, L.S.; Aminabhavi, T.M. Biodegradable polymeric microspheres of gelatin and carboxymethyl guar gum for controlled release of theophylline. Polym. Bull. 2014, 71, 1625–1643. [Google Scholar] [CrossRef]
- Thu, H.E.; Ng, S.F. Gelatine enhances drug dispersion in alginate bilayer film via the formation of crystalline microaggregates. Int. J. Pharm. 2013, 454, 99–106. [Google Scholar] [CrossRef]
- Nallathambi, G.; Ramachandran, T.; Rajendran, V.; Palanivelu, R. Effect of silica nanoparticles and btca on physical properties of cotton fabrics. Mater. Res. 2011, 14, 552–559. [Google Scholar] [CrossRef]
- Chen, M.L.; Oh, W.C. Synthesis and highly visible-induced photocatalytic activity of cnt-cdse composite for methylene blue solution. Nanoscale Res. Lett. 2011, 6, 398. [Google Scholar] [CrossRef]
- Moradi-Pour, M.; Saberi-Riseh, R.; Esmaeilzadeh-Salestani, K.; Mohammadinejad, R.; Loit, E. Evaluation of Bacillus velezensis for biological control of rhizoctonia solani in bean by alginate/gelatin encapsulation supplemented with nanoparticles. J. Microbiol. Biotechnol. 2021, 31, 1373–1382. [Google Scholar] [CrossRef]
- Melin, P.; Hakansson, S.; Schnurer, J. Optimisation and comparison of liquid and dry formulations of the biocontrol yeast pichia anomala j121. Appl. Microbiol. Biotechnol. 2007, 73, 1008–1016. [Google Scholar] [CrossRef] [PubMed]
- Canas, J.E.; Long, M.; Nations, S.; Vadan, R.; Dai, L.; Luo, M.; Ambikapathi, R.; Lee, E.H.; Olszyk, D. Effects of functionalized and nonfunctionalized single-walled carbon nanotubes on root elongation of select crop species. Environ. Toxicol. Chem. 2008, 27, 1922–1931. [Google Scholar] [CrossRef] [PubMed]
- Khodakovskaya, M.V.; de Silva, K.; Nedosekin, D.A.; Dervishi, E.; Biris, A.S.; Shashkov, E.V.; Galanzha, E.I.; Zharov, V.P. Complex genetic, photothermal, and photoacoustic analysis of nanoparticle-plant interactions. Proc. Natl. Acad. Sci. USA 2011, 108, 1028–1033. [Google Scholar] [CrossRef] [PubMed]
- Ashkavand, P.; Tabari, M.; Zarafshar, M.; Tomaskova, I.; Struve, D. Effect of SiO2 nanoparticles on drought resistance in hawthorn seedlings. Leśne Pr. Badaw. 2015, 76, 350–359. [Google Scholar] [CrossRef]
- Liang, Y.; Sun, W.; Zhu, Y.G.; Christie, P. Mechanisms of silicon-mediated alleviation of abiotic stresses in higher plants: A review. Environ. Pollut. 2007, 147, 422–428. [Google Scholar] [CrossRef]
- Pei, Z.F.; Ming, D.F.; Liu, D.; Wan, G.L.; Geng, X.X.; Gong, H.J.; Zhou, W.J. Silicon improves the tolerance to water-deficit stress induced by polyethylene glycol in wheat (Triticum aestivum L.) seedlings. J. Plant Growth Regul. 2010, 29, 106–115. [Google Scholar] [CrossRef]
- Suriyaprabha, R.; Karunakaran, G.; Yuvakkumar, R.; Rajendran, V.; Kannan, N. Silica nanoparticles for increased silica availability in maize (zea mays. L) seeds under hydroponic conditions. Curr. Nanosci. 2012, 8, 902–908. [Google Scholar] [CrossRef]
- Haghighi, M.; Afifipour, Z.; Mozafarian, M. The effect of n-si on tomato seed germination under salinity levels. J. Biol. Environ. Sci. 2012, 6, 87–90. [Google Scholar]

| Sample | Color | Density (g/cm3) | Mw | M/G Ratio * |
|---|---|---|---|---|
| ALG extracted from Macrocystis pyrifera | Light brown | 1.6 | 1.78 × 105 | 1.42 |
| ALG Sigma (A2033) | Light brown | 1.62 | 1.39 × 105 | 1.57 |
| Treatment | Root Fresh Weights | Root Dry Weights | Shoot Fresh Weights | Shoot Dry Weights | Plant Height |
|---|---|---|---|---|---|
| B. velezensis microcapsules | 2.35 a | 0.79 a | 3.26 a | 1.29 a | 16.00 a |
| B. velezensis microcapsules + P. drechsleri | 2.21 b | 0.69 a | 3.13 a | 1.14 a | 14.33 b |
| Free B. velezensis | 2.19 b | 0.68 a | 3.09 a | 1.12 a | 13.33 b |
| Free B. velezensis + P. drechsleri | 1.81 c | 0.38 b | 2.65 b | 0.64 b | 11.66 c |
| Microcapsules without bacteria | 1.75 c | 0.3b c | 2.51 b | 0.62 b | 10.66 c |
| P. drechsleri | 1.29 d | 0.21 c | 2.00 c | 0.32 c | 6.66 e |
| Control | 1.75 f | 0.25 c | 2.48 b | 0.53 bc | 8.33 d |
Publisher’s Note: MDPI stays neutral with regard to jurisdictional claims in published maps and institutional affiliations. |
© 2022 by the authors. Licensee MDPI, Basel, Switzerland. This article is an open access article distributed under the terms and conditions of the Creative Commons Attribution (CC BY) license (https://creativecommons.org/licenses/by/4.0/).
Share and Cite
Moradi Pour, M.; Saberi Riseh, R.; Skorik, Y.A. Sodium Alginate–Gelatin Nanoformulations for Encapsulation of Bacillus velezensis and Their Use for Biological Control of Pistachio Gummosis. Materials 2022, 15, 2114. https://doi.org/10.3390/ma15062114
Moradi Pour M, Saberi Riseh R, Skorik YA. Sodium Alginate–Gelatin Nanoformulations for Encapsulation of Bacillus velezensis and Their Use for Biological Control of Pistachio Gummosis. Materials. 2022; 15(6):2114. https://doi.org/10.3390/ma15062114
Chicago/Turabian StyleMoradi Pour, Mojde, Roohallah Saberi Riseh, and Yury A. Skorik. 2022. "Sodium Alginate–Gelatin Nanoformulations for Encapsulation of Bacillus velezensis and Their Use for Biological Control of Pistachio Gummosis" Materials 15, no. 6: 2114. https://doi.org/10.3390/ma15062114
APA StyleMoradi Pour, M., Saberi Riseh, R., & Skorik, Y. A. (2022). Sodium Alginate–Gelatin Nanoformulations for Encapsulation of Bacillus velezensis and Their Use for Biological Control of Pistachio Gummosis. Materials, 15(6), 2114. https://doi.org/10.3390/ma15062114

